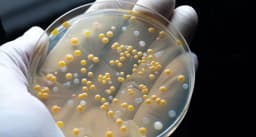
Stillmeadow, Inc. logo

Stillmeadow, Inc.
Sugar Land, Texas
Tests Offered
Coliform / BacteriaIron / ManganeseLeadPesticides / Herbicides
Lab Details
12852 Park 1 Dr, Sugar Land, Texas, 77478
(281) 240-8828
3.3(6 reviews)
TNI Code: TNI00131
🧪 Drop-Off OnlyVisit Website →
Sugar Land, Texas